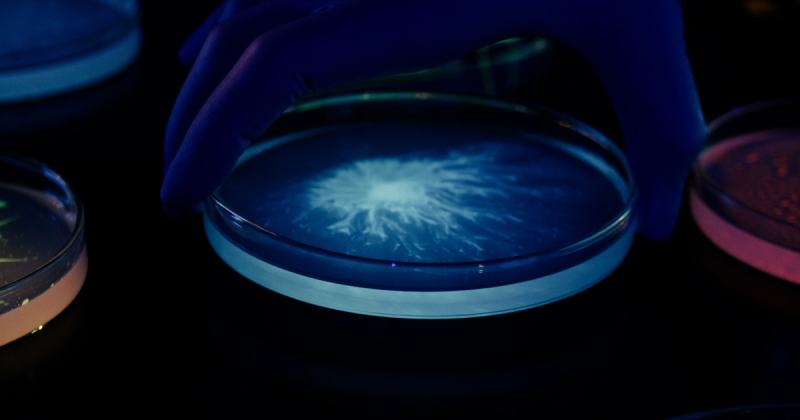

Comunicat de presă
L'Oréal a anunțat finalizarea procesului de achiziție a companiei daneze Lactobio, lider de piață în cercetarea probioticelor și a microbiomului, cu sediul în Copenhaga. Achiziția strategică se bazează pe 20 de ani de cercetare avansată realizată de L'Oréal în domeniul științific al microbiomului, perioadă în care compania și-a aprofundat cunoștințele despre microorganismele care trăiesc pe suprafața pielii, consolidând, astfel, poziționarea Grupului L'Oréal drept lider în acest domeniu.
Achiziția aduce noi oportunități din punct de vedere științific, inclusiv valorificarea expertizei în microbiom a Lactobio și a portofoliului semnificativ de produse brevetate al companiei, pentru a dezvolta noi soluții cosmetice sigure și eficiente, folosind bacterii vii.
Compania Lactobio a fost fondată în 2017 de către Søren Kjærulff, Ph.D., și Charlotte Vedel, Ph.D. care au dezvoltat o platformă unică de descoperire a microbiomului, precum și o metodă de screening pentru a selecționa cele mai eficiente și sigure tulpini. Aceste probiotice de precizie, create dintr-o mare biobancă de bacterii lactobacillus, vor fi utilizate în dezvoltarea de formule topice cu bacterii vii, inspirate din natură, pentru a oferi numeroase beneficii pielii și părului.
“Integrarea Lactobio în procesul nostru de cercetare avansată este complementară: cunoștiințele științifice solide și progresele tehnologice ale L'Oréal, împreună cu formulările de foarte bună calitate ale Lactobio pe bază de organisme vii, vor accelera semnificativ cercetările noastre asupra științei microbiomului deservind domeniul beauty. Unindu-ne forțele, ne propunem să dezvoltăm o nouă generație de produse cosmetice care vor utiliza inovații de ultimă generație în procesul de formulare, pentru a oferi produse probiotice și postbiotice bazate pe știință, atingând noi niveluri de performanță.”, a declarat Anne Colonna, Global Head of Advanced Research L'Oréal Groupe.
“Danemarca are o istorie lungă în inovare bazată pe microorganisme vii, aplicată în alimentație, agricultură și sănătate. Tocmai în acest context am fost inspirați să fondăm Lactobio. Sunt deosebit de mândru de realizările echipei noastre și sunt entuziasmat de ceea ce ne oferă viitorul ca parte a L'Oréal Groupe, unde putem aplica cercetarea microbiomului către noi domenii de inovație în materie de frumusețe pentru oamenii din întreaga lume.”, a adăugat Søren Kjærulff, Fondator & Chief Scientific Officer Lactobio.

Singurătatea doare! Tu o poți vindeca! Campanie pentru susținerea nevoilor urgente ale vârstnicilor din România
”Nu mă lăsa să mor” - o poveste de ficțiune despre realitatea dureroasă a singurătății, din 5 decembrie în cinematografe
O joacă a unui tânăr român a dus la reinventarea sistemului de returnare a ambalajelor
McHappy Day 2025®: când faptele bune țin familiile împreună